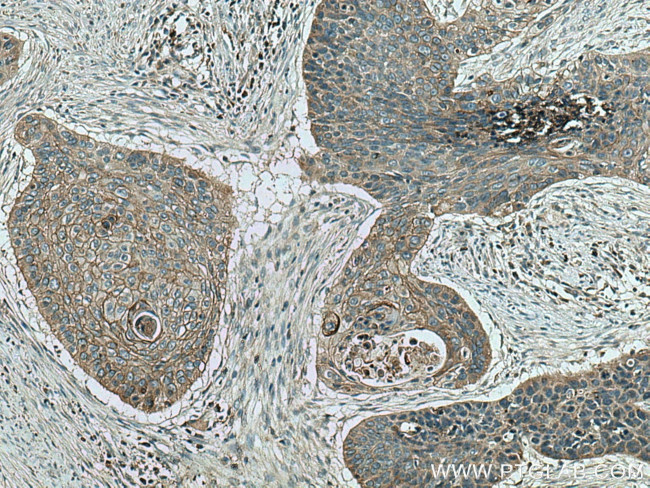
LYNX1 Antibody in Immunohistochemistry (Paraffin) (IHC (P))

Search
Proteintech
LYNX1 Polyclonal Antibody
{{$productOrderCtrl.translations['antibody.pdp.commerceCard.promotion.promotions']}}
{{$productOrderCtrl.translations['antibody.pdp.commerceCard.promotion.viewpromo']}}
{{$productOrderCtrl.translations['antibody.pdp.commerceCard.promotion.promocode']}}: {{promo.promoCode}} {{promo.promoTitle}} {{promo.promoDescription}}. {{$productOrderCtrl.translations['antibody.pdp.commerceCard.promotion.learnmore']}}
产品信息
13373-1-AP
种属反应
宿主/亚型
分类
类型
抗原
偶联物
形式
浓度
规格
纯化类型
保存液
内含物
保存条件
运输条件
产品详细信息
Immunogen sequence: LDCHVCAYN GDNCFNPMRC PAMVAYCMTT RTSAAEAIWC HQCTGFGGCS HGSRCLRDST HCVTTATRVL SNTEDLPLVT KMCHIGCPDI PSLGLGPYVS IACCQTSLCN HD (21-131 aa encoded by BC032306)
靶标信息
LYNX1 acts in different tissues through interaction to nicotinic acetylcholine receptors (nAChRs). The proposed role as modulator of nAChR activity seems to be dependent on the nAChR subtype and stoichiometry, and to involve an effect on nAChR trafficking and its cell surface expression, and on single channel properties of the nAChR inserted in the plasma membrane. Modulates functional properties of nicotinic acetylcholine receptors (nAChRs) to prevent excessive excitation, and hence neurodegeneration. Enhances desensitization by increasing both the rate and extent of desensitization of alpha-4:beta-2-containing nAChRs and slowing recovery from desensitization. Promotes large amplitude ACh-evoked currents through alpha-4:beta-2 nAChRs. Is involved in regulation of the nAChR pentameric assembly in the endoplasmic reticulum. Shifts stoichiometry from high sensitivity alpha-4(2):beta-2(3) to low sensitivity alpha-4(3):beta-2(2) nAChR. In vitro modulates alpha-3:beta-4-containing nAChRs. Reduces cell surface expression of (alpha-3:beta-4)(2):beta-4 and (alpha-3:beta-4)(2):alpha-5 nAChRs suggesting an interaction with nAChR alpha-3(-):(+)beta-4 subunit interfaces and an allosteric mode. Corresponding single channel effects characterized by decreased unitary conductance, altered burst proportions and enhanced desensitization/inactivation seem to depend on nAChR alpha:alpha subunit interfaces and are greater in (alpha-3:beta-2)(2):alpha-3 when compared to (alpha-3:beta-2)(2):alpha-5 nAChRs. Prevents plasticity in the primary visual cortex late in life.
仅用于科研。不用于诊断过程。未经明确授权不得转售。
篇参考文献 (0)
生物信息学
蛋白别名: Endogenous prototoxin LYNX1; GC26; Ly-6 neurotoxin-like protein 1; Ly-6/neurotoxin-like protein 1; secreted Ly-6/uPAR domain-containing protein 2; secreted Ly-6/uPAR-related protein 2; Testicular tissue protein Li 112
基因别名: AI838844; LYNX1; SLURP-2
UniProt ID: (Human) P0DP58, (Mouse) P0DP60
Entrez Gene ID: (Human) 66004, (Mouse) 23936, (Rat) 300018